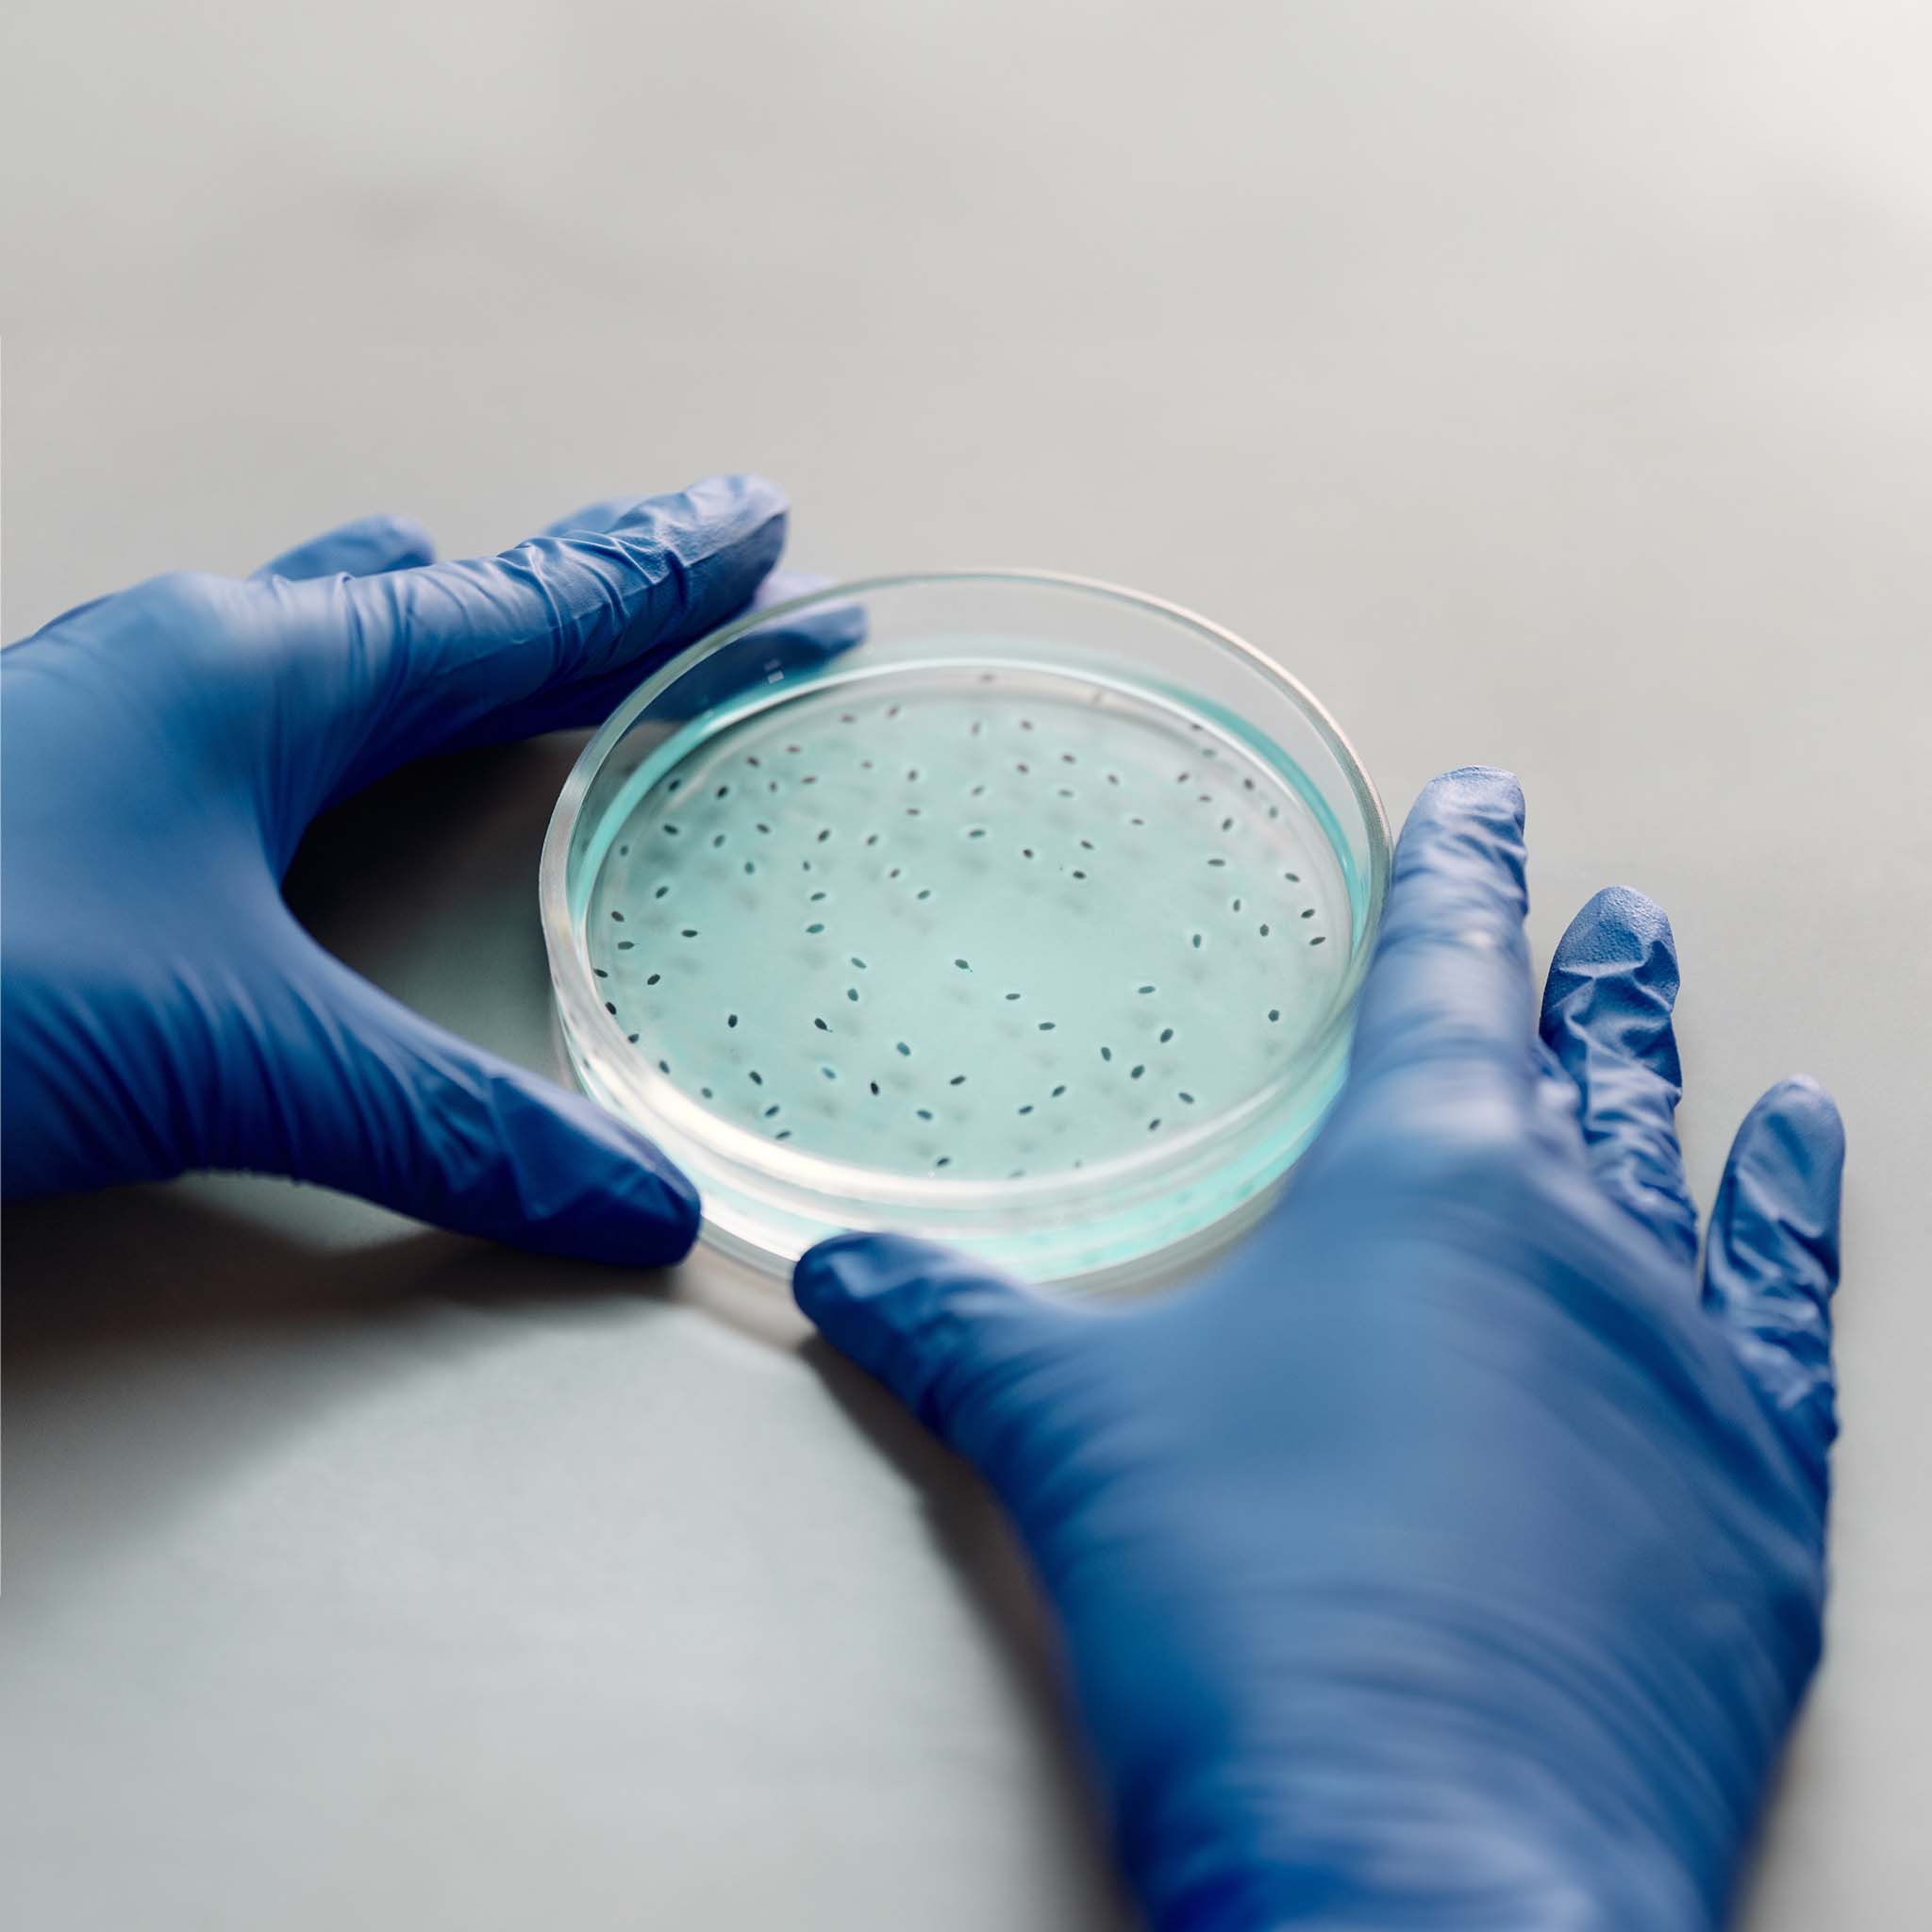

Not all Melatonin is Created Equal: The Sleep Dilemma
When it comes to sleep, your body relies on melatonin. This hormone, naturally produced by the pineal gland, helps regulate our sleep-wake cycles. However, not all melatonin supplements are created...

Autism vs. Melatonin: The Bedtime Battle
Navigating bedtime can be particularly tough for children with Autism Spectrum Disorder (ASD). If your child struggles with sleep, you’re not alone. Many kids on the autism spectrum face sleep issu...
What is a colony-forming unit?
Colony-Forming Units (CFUs) are essential components of probiotic supplements, playing a crucial role in maintaining a healthy gut microbiome. In this blog, we will explore the significance of CFUs...

Common Questions about Teething and How to help your baby
Written by Chelsea Spooner, Now that you have read the 7 Steps in our prior blog post, let's answer some frequently asked questions surrounding teething. 1. Is it normal for my child to have a feve...

7 Steps to Helping your Baby Through the Teething Pain
Written by Chelsea Spooner If you are a first time mom, or it’s been a minute since you have had a teething baby, you might be feeling unsure or intimidated by the whole teething process. But rest ...

Common Questions about Kids and Sleep and Why Sleep is so important.
Written by Chelsea Spooner, What are the signs and symptoms of insufficient sleep? Problems paying attention and poor school performance Outbursts and unnecessary crying Constantly sick from ...



